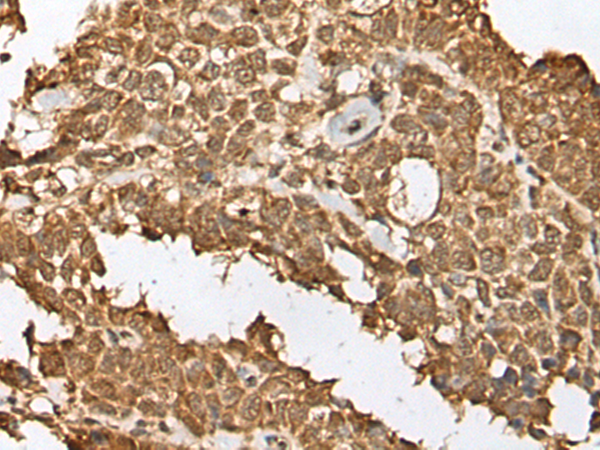
一抗

中文名稱: 兔抗RBL2多克隆抗體
英文名稱: Anti-RBL2 rabbit polyclonal antibody
別 名: Rb2; P130
儲(chǔ) 存: 冷凍(-20℃)
抗 原: RBL2
宿 主: Rabbit
反應(yīng)種屬: Human, Mouse, Rat
相關(guān)類別: 一抗
標(biāo) 記 物: Unconjugate
克隆類型: rabbit polyclonal
Background:
Retinoblastoma-like protein 2 is a protein that in humans is encoded by the RBL2 gene. Key regulator of entry into cell division. Directly involved in heterochromatin formation by maintaining overall chromatin structure and, in particular, that of constitutive heterochromatin by stabilizing histone methylation. Recruits and targets histone methyltransferases SUV420H1 and SUV420H2, leading to epigenetic transcriptional repression. Controls histone H4 'Lys-20' trimethylation.
Applications:
ELISA, WB, IHC
Name of antibody:
RBL2
Immunogen:
Synthetic peptide of human RBL2
Full name:
retinoblastoma-like 2
Synonyms:
Rb2; P130
SwissProt:
Q08999
ELISA Recommended dilution:
5000-10000
IHC positive control:
Human lung cancer and human brain
IHC Recommend dilution:
30-150
WB Predicted band size:
128 kDa
WB Positive control:
Lncap cell
WB Recommended dilution:
200-1000
技術(shù)規(guī)格



 購(gòu)物車
購(gòu)物車 幫助
幫助
 021-54845833/15800441009
021-54845833/15800441009